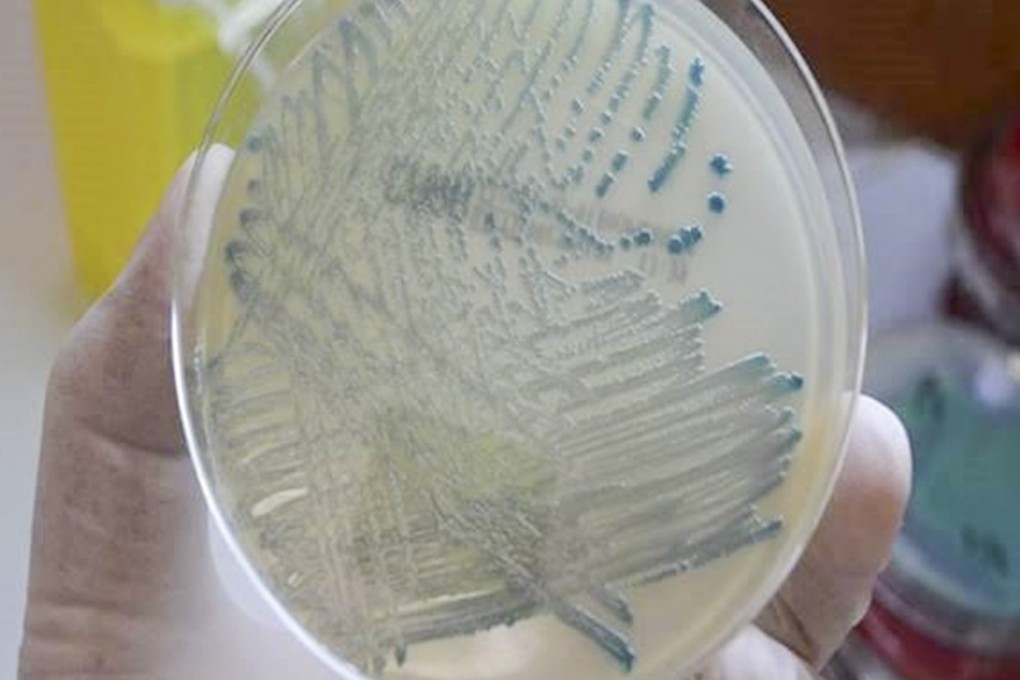
The number of patients detected with CPE was 473 last year, up from 340 in 2016. Photo: Hospital Authority

Full screening for superbug begins as Hong Kong hospitals battle rising number of cases
Number of CPE cases increased by 40 per cent last year, but city hospitals can now test for the bacteria on site
Hong Kong hospital bosses have started providing full screenings for a type of superbug – dubbed “enemy No 1” – to increase the speed of detection and isolation, after the number of cases increased by 40 per cent last year.
Anyone already in hospital and deemed high-risk will be checked for carbapenemase-producing enterobacteriaceae (CPE), with the tests carried out on site.
On Friday Dr Dominic Tsang Ngai-chong, chief infection control officer at the Hospital Authority, which manages the city’s 43 public hospitals and institutions, noted that the number of patients detected with CPE last year was 473, up from 340 in 2016.
The benefit is that you can know [about the detected cases] quickly and can immediately isolate the patients, so they will not spread it to neighbouring patients
The bacteria are resistant to the carbapenem class of antibiotics, considered the drug of last resort for such infections.
Most people who carry CPE have no symptoms, but it can cause urinary tract infections, pneumonia, bladder or kidney infections, bloodstream infections and can be life-threatening.
While CPE can still be treated by colistin, another type of antibiotic, doctors say the decades-old drug is not very effective and has negative side effects.
But Tsang noted that more than 90 per cent of those detected with the bug were just carriers, with fewer than 10 people having infected with the bacteria.
He attributed the high number of cases detected to stringent screening, adding that 473 was a small number compared with the 118,442 cases tested.